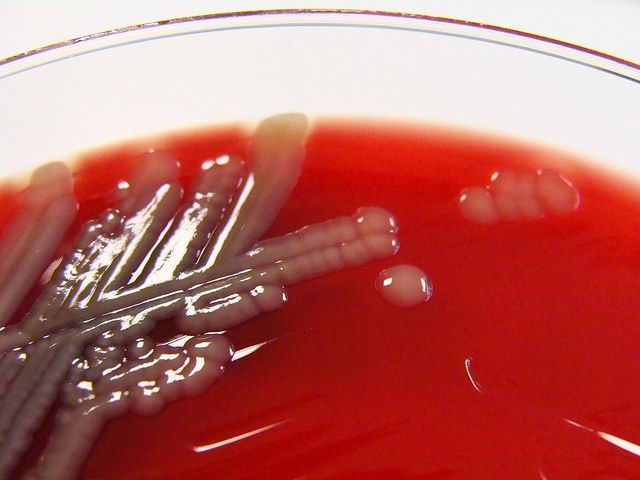
6939092725_4483824a9e_z

น่ากลัวมาก!! โรคแบคทีเรียกินเนื้อ (Flesh-Eating Bacteria)
ข่าวชายถูกเงี่ยงปลาตำ เกิดการเน่าตายของเนื้อเยื่อ ติดเชื้อเสียชีวิต จากอะไร ?
“เนโครไทซิง ฟาสซิไอติส: Necrotizing Fasciitis ” “ภาวะโรคแบคทีเรียกินเนื้อ” เป็นอย่างไร
"Necrotizing Fasciitis" นั้นไม่ใช่ชื่อของเชื้อแบคทีเรีย แต่คือภาวะที่เกิดการติดเชื้อแบบรุนแรงและรวดเร็วของชั้นใต้ผิวหนังและสามารถแพร่กระจายเชื้อลึกลงไปถึงผิวหนังบริเวณที่หุ้มกล้ามเนื้อ และบริเวณรอบๆ ได้ ถ้าหากไม่ได้รับการวินิฉัยและรักษาให้ทันท่วงทีอาจทําให้เกิดการทําลายเนื้อเยื่อบริเวณดังกล่าว เกิดพิษต่อระบบต่าง ๆ ของร่างกายและทําให้เสียชีวิตได้
โรค Necrotizing Fasciitis คือโรคที่เกิดจากเชื้อแบคทีเรีย ที่สามารถทำลายผิวหนัง ไขมัน และเนื้อเยื่อที่ห่อหุ้มกล้ามเนื้อได้ภายในรวดเร็วดังที่กล่าวไปแล้ว บางครั้งเรียกโรคนี้ว่าโรคแบคทีเรียกินเนื้อ (Flesh-Eating Bacteria) ถ้าเกิดกับบริเวณอวัยวะสืบพันธุ์จะเรียกว่าโรคหนังเน่า (Fournier gangrene) โรคนี้พบไม่บ่อย แต่เป็นโรคที่ค่อนข้างน่ากลัว โดยพบว่าประมาณ 1 ใน 4 ของคนที่เกิดภาวะนี้จะตาย ซึ่งมีผู้คนมากมายที่ก่อนจะได้รับเชื้อนั้นมีร่างกายแข็งแรง แต่อัตราเสี่ยงการติดเชื้อจะมากขึ้นเมื่อ
1. ภูมิคุ้มกันต่ำ
2. มีปัญหาสุขภาพเรื้อรัง เช่น เป็นโรคเบาหวาน มะเร็ง หรือ โรคตับ โรคไต
3. มีแผลที่ผิวหนัง หรือมีแผลผ่าตัด
4. เพิ่งเป็นโรคอีสุกอีใส หรือมีการติดเชื้อจากไวรัสซึ่งทำให้เกิดผื่นคัน
5. ใช้ยาสเตียรอยด์ ซึ่งทำให้ร่างกายต้านทานเชื้อได้ต่ำลง
สาเหตุของโรคนั้นเกิดจากแบคทีเรียได้หลายชนิด ซึ่งแบคทีเรียบางชนิดนั้นก็เป็นสาเหตุของการติดเชื้อ เช่น โรคเจ็บคอสเตรปโธรท (Strep throat) เป็นโรคเกิดจากร่างกายติดเชื้อแบคทีเรียชนิด กรุ๊ป เอ สเตรปโตคอกคัส (Group A beta-hemolytic streptococcus หรือ เรียกย่อว่า แกส/GAS หรือ GABHS) และโรคแผลพุพอง เป็นการติดเชื้อแบคทีเรียที่ผิวหนังชั้นตื้น (Impetigo) ซึ่งส่วนใหญ่แล้วลักษณะการติดเชื้อแบบนี้ไม่มีความรุนแรง แต่ในบางเคสซึ่งมีน้อยมาก กลับสามารถทำอันตรายได้อย่างใหญ่หลวง
โรคนี้เกิดเมื่อแผลติดเชื้อจากแบคทีเรีย เช่น เมื่อโดนแมลงกัด ถูกความร้อนเผาไหม้ มีบาดแผล และยังสามารถติดเชื้อได้จากแผลที่เกิดจากการสัมผัสน้ำในมหาสมุทร น้ำเค็มจากบ่อเลี้ยงปลาหรือสัตว์เปลือกแข็ง รวมทั้งการบาดเจ็บจากการสัมผัสพวกสัตว์ทะเลเช่นปู การผ่าตัดลำไส้หรือเนื้องอก หรือบาดแผลที่ถูกกระสุนปืนในลำไส้ กล้ามเนื้อที่อ่อนล้าหรือแผลฟกช้ำ ถึงแม้ว่าจะไม่มีการบาดเจ็บใดๆที่ผิวเลย
แบคทีเรียก่อโรคนี้สามารถติดต่อจากคนสู่คนได้โดยเฉพาะคนใกล้ชิด จากการสัมผัสบาดแผลจากคนที่ติดเชื้อ แต่ก็เกิดขึ้นได้ยาก ยกเว้นคนสัมผัสมีบาดแผล เป็นอีสุกอีใส หรือมีภูมิคุ้มกันต่ำ
เนื้อเยื่อของผู้มีภาวะ Necrotizing fasciitis
อาการของโรค
อาการส่วนมากมักเกิดขึ้นทันทีหลังมีบาดแผล ซึ่งจำเป็นต้องให้ยารักษาที่ถูกต้องถ้าอาการดีขึ้นภายใน 24-36 ชั่วโมง และแย่ลงทันทีทันใด อาการปวดจะเลวร้ายลงผิดกับขนาดบาดแผลที่เกิดขึ้น หรือการบาดเจ็บที่เกิดขึ้น และจะมีอาการดังนี้ คือ ผิวหนังมีสีแดง บวม และเมื่อสัมผัสจะรู้สึกว่าผิวหนังร้อน มีไข้และหนาวสั่น มีอาการคลื่นไส้พะอืดพะอม อาเจียน ท้องเสีย
การติดเชื้อจะลุกลามอย่างรวดเร็ว เร็วจนสามารถคุกคามถึงแก่ชีวิตได้ ผู้ป่วยจะมีอาการช็อคและจะถูกทำลายทั้งผิวหนัง ไขมัน แล้วเนื้อเยื่อที่ปกคลุมกล้ามเนื้อ เรียกว่าว่าเป็นเนื้อร้าย gangrene ภาวะ Necrotizing fasciitis นี้ทำให้การทำงานของอวัยวะล้มเหลวและตายได้ในที่สุด
การวินิจฉัยโรค Necrotizing fasciitis
แพทย์จะวินิจฉัยอาการติดเชื้อโดยดูจากความรวดเร็วของอาการของโรคที่เริ่มเกิดขึ้นและความรวดเร็วในการลุกลาม เนื้อเยื่อที่ติดเชื้ออาจจะถูกตัดไปตรวจชนิดของแบคทีเรีย การตรวจเลือด มีการเอ็กซเรย์ ทำ CT scan หรือ MRI scan เพื่อดูอาการบาดเจ็บของอวัยวะหรือเพื่อดูว่าการกระจายของการติดเชื้อมีมากเพียงใด
การรักษา
ต้องทำการรักษาทันทีเพื่อป้องกันการตาย มีดังนี้
► ให้ยาต้านจุลชีพที่ออกฤทธิ์ต่อแบคมีเรียทั้งแกรมบวกและแกรมลบ (broad-spectrum antibiotics ทางเส้นเลือดดำในทันที
► ผ่าตัดเพื่อบรรเทาอาการเจ็บปวด และเอาเนื้อเยื่อที่ตายแล้วออก
► ในบางรายให้ยาเฉพาะที่เรียกว่า donor immunoglobulins (antibodies) เป็นยาที่เพิ่มภูมิคุ้มกันเพื่อให้ร่างกายต่อสู้กับการติดเชื้อ
► นอกจากนี้อาจมีการปลูกถ่ายเนื้อเยื่อหลังจากหายจากการติดเชื้อเพื่อช่วยรักษาผิวบริเวณนั้น และเพื่อให้ผิวดูดีขึ้น
► การตัดอวัยวะที่มีการติดเชื้อออก เช่น แขน ขา
► การบำบัดโดยการให้ออกซิเจนบริสุทธิ์ที่ความดันสูง คือการกระตุ้นให้เกิดการสร้างเส้นเลือดขึ้นใหม่บริเวณที่ขาดเลือดไปเลี้ยง (hyperbaric oxygen therapy: HBOT) โดยจำเพาะกับแบคทีเรียที่ทำให้ติดเชื้อ

ส่วนที่วงกลมแสดงช่องแก็สในเนื้อเยื่อที่เกิดจากเชื้อแบคทีเรีย
บริเวณสีชมพูตรงกลาง แสดงเนื้อเยื่อที่ตายจากการติดเชื้อ
การติดเชื้อนั้นมี 2 แบบ
1. TYPE I INFECTION (Polymicrobial infection)
เป็นการติดเชื้อที่มีเชื้อมากกว่า 1 ชนิด โดยเป็นการติดเชื้อของ Anaerobe bacteria ( เช่น Bacteroides fragilis, Clostidium, Peptostreptococcus) ร่วมกับ Aerobe bacteria (เช่น E.Coli, Enterobacter, Klebsiella, Proteus, non- group A streptococcus) มักพบบริเวณศีรษะ คอ แขน เท้า ช่องเชิงกราน แผลกดทับโดยส่วนใหญ่แล้วจะเกิดจากการฉีกขาดของ เยื่อบุของระบบทางเดินอาหารหรือทางเดินปัสสาวะ ซึ่งเป็นได้ตั้งแต่มะเร็ง, ริดสีดวงทวาร, ภาวะลําไส้โป่งพองเป็นกระเปาะ (diverticulum), แผลปริที่ขอบทวารหนัก (anal fissure), ภาวะที่มีการฉีกขาดของระบบทางเดินปัสสาวะ, การผ่าตัดบริเวณช่องท้องและการได้รับบาดแผลแทงทะลุท้อง ปัจจัยที่เพิ่มความเสี่ยงต่อการติดเชื้อประเภทนี้คือ โรคเบาหวาน โรคหลอดเลือดส่วนปลาย
2. TYPE II INFECTION (Monomicrobial infection)
เป็นการติดเชื้อ Group A Streptococcus เป็นหลัก ซึ่งเชื้อชนิดนี้พบได้มากถึง 60% ของกลุ่มนี้ บางครั้งการติดเชื้อชนิดนี้อาจมีเชื้ออื่น ๆ ร่วมด้วยได้ ซึ่งพบมากร่วมกับ Staphylococcus aureus ส่วนเชื้ออื่น ๆ ที่อยูในกลุ่ม monomicrobial infection เช่น Vibrio vulnificus, Clostidium perfringens, Methicillin-resistant S.aureus (MRSA) นั้นพบได้น้อย
ลักษณะการติดเชื้อจะเข้าสู่ร่างกายในภาวะมีแบคทีเรียในเลือด อาจมีอยู่เพียงชั่วคราวแล้วหายไป (transient bacteremia) และมีการเจริญพันธุ์ในบริเวณที่มีการได้รับบาดเจ็บเล็กน้อย เช่น บริเวณที่มีการฟกชํ้าหรือบริเวณที่มีการปวดเมื่อยของกล้ามเนื้อ อาจเกิดภาวะแทรกซ้อนที่สําคัญได้คือ streptococcal toxic shock syndrome
ภาพลักษณะทางกายภาพของ Aeromonas hydrophila ผ่านกล้องจุลทรรศน์ และย้อมสี
Aeromonas hydrophila บนอาหารเลี้ยงเชื้อ Columbia Horse Blood Agar แยกได้จากเลือดของผู้ป่วยที่ท้องร่วงรุนแรงรายหนึ่ง
แบคทีเรียกลุ่ม Aeromonas หนึ่งในสาเหตุจากข่าวว่าน่าจะเป็นเชื้อที่ทำให้เกิดการติดเชื้อนั้นเป็นแบคทีเรียชนิดแกรมลบ ไม่มีการสร้างสปอร์ มีรูปร่างแบบแท่ง เติบโตทั้งในภาวะที่มีและไม่มีออกซิเจน พบได้ทั่วไปและอาศัยอยู่ในแหล่งน้ำ ที่ผ่านมาแบคทีเรียสกุล Aeromonas ถูกจัดอยู่ในวงศ์ Vibrionaceae แต่ก็มีการเสนอให้จัดเป็นวงศ์ของตัวแบคทีเรียนี้เองคือวงศ์ Aeromonadaceae แบคทีเรีย Aeromonas มีลักษณะทางชีวเคมีหลายอย่างร่วมกับแบคทีเรียในวงศ์ Enterobacteriaceae จากการที่แบคทีเรียนี้มีการเปลี่ยนแปลงแรกเริ่มโดยเป็น oxidase-positive
Aeromonas เป็นสกุลแบคทีเรียที่สามารถพบได้ทั่วไปในสิ่งแวดล้อม พบได้ในแหล่งน้ำทุกชนิดในโลก ในอาหารและดิน สกุล Aeromonas มีประมาณ 16 ชนิด ชนิดที่รู้จักกันมากที่สุดก็คือ Aeromonas hydrophila ลักษณะทางกายภาพของแบคทีเรีย Aeromonas นั้นเหมือนกับแบคทีเรียในกลุ่ม coliform และสามารถแยกออกจากกันได้ในสภาพแวดล้อมเดียวกัน
Aeromonas มักแยกได้จากแหล่งน้ำทั่วๆไป ทั้งแหล่งน้ำจืด ปากแม่น้ำ น้ำกร่อย น้ำเค็ม Aeromonas นั้นเป็นจุลินทรีย์ประจำถิ่นหรือ normal flora ในแหล่งน้ำ และการแบคทีเรียเหล่านี้ก็ไม่ได้บ่งชี้ว่าน้ำนั้นมีมลพิษแต่อย่างใด และยังสามารถพบได้ในอาหารหลายชนิด รวมทั้งเนื้อแดง (เนื้อวัว เนื้อหมู เนื้อแกะ) สัตว์ปีก สัตว์เปลือกแข็ง ปลา รวมทั้งพืชผัก

ภาพสัตว์ที่ติดเชื้อ Aeromonas
แบคทีเรียบางชนิดในสกุลนี้ทำให้เกิดโรคในมนุษย์ แต่ก็ไม่ทุกชนิดที่ก่อโรคในมนุษย์ การติดเชื้อ Aeromonas เป็นไปได้ 2 ทาง คือ ทางระบบการย่อยอาหารหรือทางบาดแผลที่เปิด โรคที่พบทางคลินิกจากการติดเชื้อทำให้เกิดอาการอักเสบของกระเพาะอาหารและลำไส้ และภาวะโลหิตเป็นพิษ
แบคทีเรียกลุ่ม Aeromonas กระจายอยู่ทั่วไปในสิ่งแวดล้อม และมีรายงานว่าเป็นเชื้อที่ก่อให้เกิดโรคในมนุษย์เพิ่มขึ้นอย่างต่อเนื่อง การติดเชื้อที่พบทางคลินิกนั้นมีทั้งการอักเสบของกระเพาะอาหาร ลำไส้ ผิวหนัง การถลอกของเนื้อเยื่อ และภาวะเลือดมีแบคทีเรีย การดื้อยาปฏิชีวนะนั้นเป็นต้นเหตุที่สำคัญของปัญหาในการรักษาการติดเชื้อแบคทีเรียกลุ่ม Aeromonas s นี้ สายพันธุ์ส่วนใหญ่จะไวต่อยา chloramphenicol, ciprofloxacin, co-trimoxazole และ aminoglycosides ส่วนยา amoxycillin/clavulanate และ acylureidopenicillins นั้นไม่สามารถใช้รักษาได้อย่างสม่ำเสมอเท่าที่ควร การเติมตัวยับยั้งเอนไซม์ β-lactamase ไม่ได้ไปช่วยกระตุ้นประสิทธิภาพการทำงานของ acylureidopenicillins แต่อย่างใดอย่างมีนัยสำคัญ Aztreonam carbapenems imipenem และ meropenem ยังสามารถออกฤทธิ์ได้ดี การดื้อยารุ่น 1และ 2 ในกลุ่ม cephalosporin นั้นเป็นตัวแปร ทำให้ Aeromonas มากกว่า 90% ไวต่อยาในรุ่นที่ 3
ความสามารถที่มีนัยสำคัญของแบคทีเรียนี้คือการระบุการถอดรหัสโครโมโซม ที่ไปกระตุ้นเอนไซม์ β-lactamase ร่วมกับการต้านยาปฏิชีวนะหลายชนิดทั้ง penicillins, cephalosporins, monobactams และ carbapenems ทางคลินิกเมื่อทำการแยกเชื้อ Aeromonas spp. พบว่ามีการสร้างเอนไซม์ 2 ชนิดคือ เอนไซม์ A1 serineβ-lactamase เป็นเอนไซม์ในกลุ่ม cephalosporinase และเอนไซม์ A2 metallo β-lactamase ซึ่งเป็นเอนไซม์ที่ถูกไฮโดรไลซ์ จากตัวตั้งต้นคือ β-lactam รวมทั้ง carbapenems ซึ่งการศึกษาความสัมพันธ์ของเอนไซม์เหล่านี้ทางคลินิกยังไม่ชัดเจน

ภาพจากกล้องจุลทรรศน์อิเล็คตรอนแสดงระยะการเจริญเติบโตของ Aeromonas hydrophila ที่ระยะต่างๆ
เชื้อ Aeromonas bacteria ที่พบว่ามีรายงานการก่อให้เกิดโรคนั้นตัวหนึ่งคือ Aeromonas hydrophila ซึ่งเป็นชนิดที่พบในแหล่งน้ำจืดและน้ำกร่อย บางสายพันธุ์พบว่าทำให้เกิดอาการป่วยในปลาและสัตว์ครี่งบกครึ่งน้ำเหมือนกับที่พบในคนที่ได้รับการติดเชื้อทางบาดแผลเปิด หรือจากทางเดินอาหารโดยได้รับปริมาณเชื้อจุลินทรีย์ที่มากพอ น้อยคนที่จะรู้จักแบคทีเรียตัวนี้ซึ่งจริงๆแล้วเป็นแบคทีเรียที่มีมากในแหล่งน้ำและเกี่ยวข้องกับการเกิดโรคในมนุษย์ เชื้อ A. hydrophila เป็นสาเหตุองการอักเสบของกระเพาะอาหารและลำไส้ หรือภาวะเลือดมีพิษในรายบุคคลได้ โดยเฉพาะคนที่มีภูมิคุ้มกันต่ำหรือผู้ป่วยมะเร็ง
ชนิดของลำไส้อักเสบนั้นสาเหตุหนึ่งมาจาก A. hydrophila ซึ่งมีอาการเหมือนเป็นอหิวาตกโรค ถ่ายเป็นน้ำซาวข้าว และมีอาการของโรคบิดเป็นถ่ายอุจจาระปนมูกเลือด พบว่านักดำน้ำแบบ scooba ที่กินน้ำจืดเข้าไปมีอาการป่วย และสามารถแยกเชื้อ A. hydrophila ได้จากอุจจาระของเขา การติดเชื้อในอีกลักษณะหนึ่งมีภาวะเลือดเป็นพิษคือมีเชื้อในเลือดและกระจายไปทั่วร่างกาย จะพบเป็นรายบุคคลซึ่งมักมีอาการป่วยอยู่
A. hydrophila นี้สามารถเพาะได้จากทั้งอุจจาระและเลือดบนอาหารเลี้ยงเชื้อที่มีเลือดเกะและยาปฏิชีวนะ amplicilin amplicilin นั้นใส่เพื่อป้องกันการเจริญเติบโตของเชื้อตัวอื่นๆ ซึ่งเชื้อ A. hydrophila การผลิตสาร enterotoxins ที่เชื่อว่าเป็นสาเหตุของอาการอักเสบดังที่ได้กล่าวมาของเชื้อยืนยันโดยใช้วิธีการเพาะเลี้ยงเนื้อเยื่อ
เชื้อ A. hydrophila จะกระจายทั่วร่างกาย และทำให้ร่างกายสามารถติดเชื้อได้ในคนที่มีภาวะภูมิคุ้มกันบกพร่อง คนที่มีความเสี่ยง เช่น ผู้ป่วยมะเร็งเม็ดเลือดขาวหรือลูคีเมีย มะเร็ง โรคตับแข็ง และผู้ป่วยที่รักษาด้วยยากดภูมิคุ้มกันหรือผู้ป่วยมะเร็งที่ทำการรักษาด้วยเคมี
เปิด 3 ประเทศยอดฮิตที่เด็ก สปป.ลาว นิยมไปเรียนต่อต่างประเทศ
กิจวัตรของพระธุดงค์ คืออะไร ใช้ชีวิตอย่างไรในแต่ละวัน
AI วิเคราะห์สถิติ 20 ปีหวยงวด 16 ก.ค.69 ให้เลขท้าย 2 ตัวเน้นๆ!
ทำไมปุ่ม F และ J ถึงมีขีดนูนเล็ก ๆ บนคีย์บอร์ด
5 ของเล่นยุค 90 ที่ยังมีมูลค่าสูงในตลาดนักสะสม
จังหวัดอันดับหนึ่งของไทย ที่โดดเด่นเรื่องนางงามมากที่สุด
5 รถมอเตอร์ไซค์ที่ทำตลาดในไทยได้ ไม่ดี และมียอดขายไม่สูง
พ.ร.บ. รถยนต์ คืออะไร ทำไมเจ้าของรถต้องต่อทุกปี
แนวทางเลข "ม้าวิ่ง" 16 กรกฏาคม 2569
ทำไมกฎหมายต้องกำหนดอายุขั้นต่ำของผู้ขับขี่
ดราม่าดอกไม้ 4 กลีบ! ศาลจีนสั่ง Molly Tea ชดใช้กว่า 55 ล้านบาทให้ Louis Vuitton
เขตของกรุงเทพมหานคร ที่มีสภาพเป็นพื้นที่ชนบทมากที่สุด
5 ของเล่นยุค 90 ที่ยังมีมูลค่าสูงในตลาดนักสะสม
ทำไมปุ่ม F และ J ถึงมีขีดนูนเล็ก ๆ บนคีย์บอร์ด
รู้จัก 5 นักธุรกิจใหญ่ลาว รวยเงียบแต่บทบาทไม่ธรรมดา
กิจวัตรของพระธุดงค์ คืออะไร ใช้ชีวิตอย่างไรในแต่ละวัน
พ.ร.บ. รถยนต์ คืออะไร ทำไมเจ้าของรถต้องต่อทุกปี
6 นักแสดงที่เคยไร้บ้าน ก่อนก้าวสู่ฮอลลีวูด